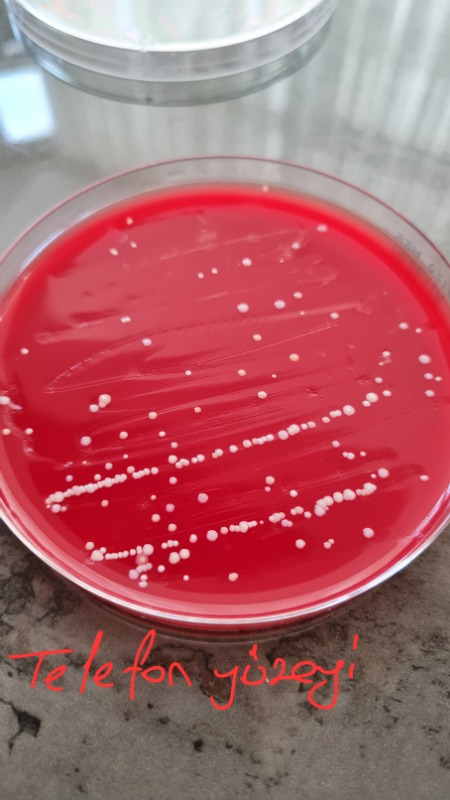
visual-comment-img

Ek 75 TL Kupon
Kanz Htc-1 Beyaz Hygrometre-Termometre Yüksek Hassasiyetli Ölçüm Modeli ile
Ürün puanı 4.5, 745 değerlendirme


44 değerlendirme
Satıcı puanı, Hepsiburada.com müşterileri tarafından verilen teslimat süresi, paketleme ve genel alışveriş deneyimi puanlarına göre hesaplanmaktadır.